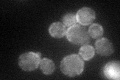
YMR266W
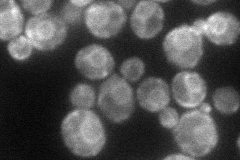
YMR266W
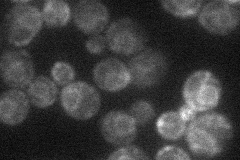
YMR266W
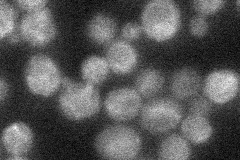
YMR266W
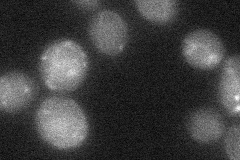
YMR266W
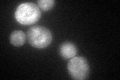
YMR266W
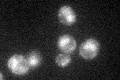
YMR266W
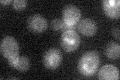
YMR266W

View description
Membrane protein of unknown function; overexpression suppresses NaCl sensitivity of sro7 mutant cells by restoring sodium pump (Ena1p) localization to the plasma membrane
Localization:
Intensity:
Fold change:
Significance:
-
C’ GFP library in SD
cell periphery46.8 -
N' NOP1pr-GFP in SD
cell periphery,ER55.229 -
N' TEF2pr-mCherry in SD
ER23.9211 -
N' NATIVEpr-GFP in SD
punctate22.6166 -
N' TEF2pr-VC and Cyto-VN in SD
below threshold24.427 -
C’ GFP library in SD+DTT
cell periphery42.060.89No -
C’ GFP library in SD+H2O2

cell periphery43.080.92No -
C’ GFP library in Starvation Media
cell periphery420.89No -
C’ GFP library on the background of Pup2-DaMP
vacuole -
C’ GFP library on the background of CCT mutant

cell periphery38.37650.81999No
